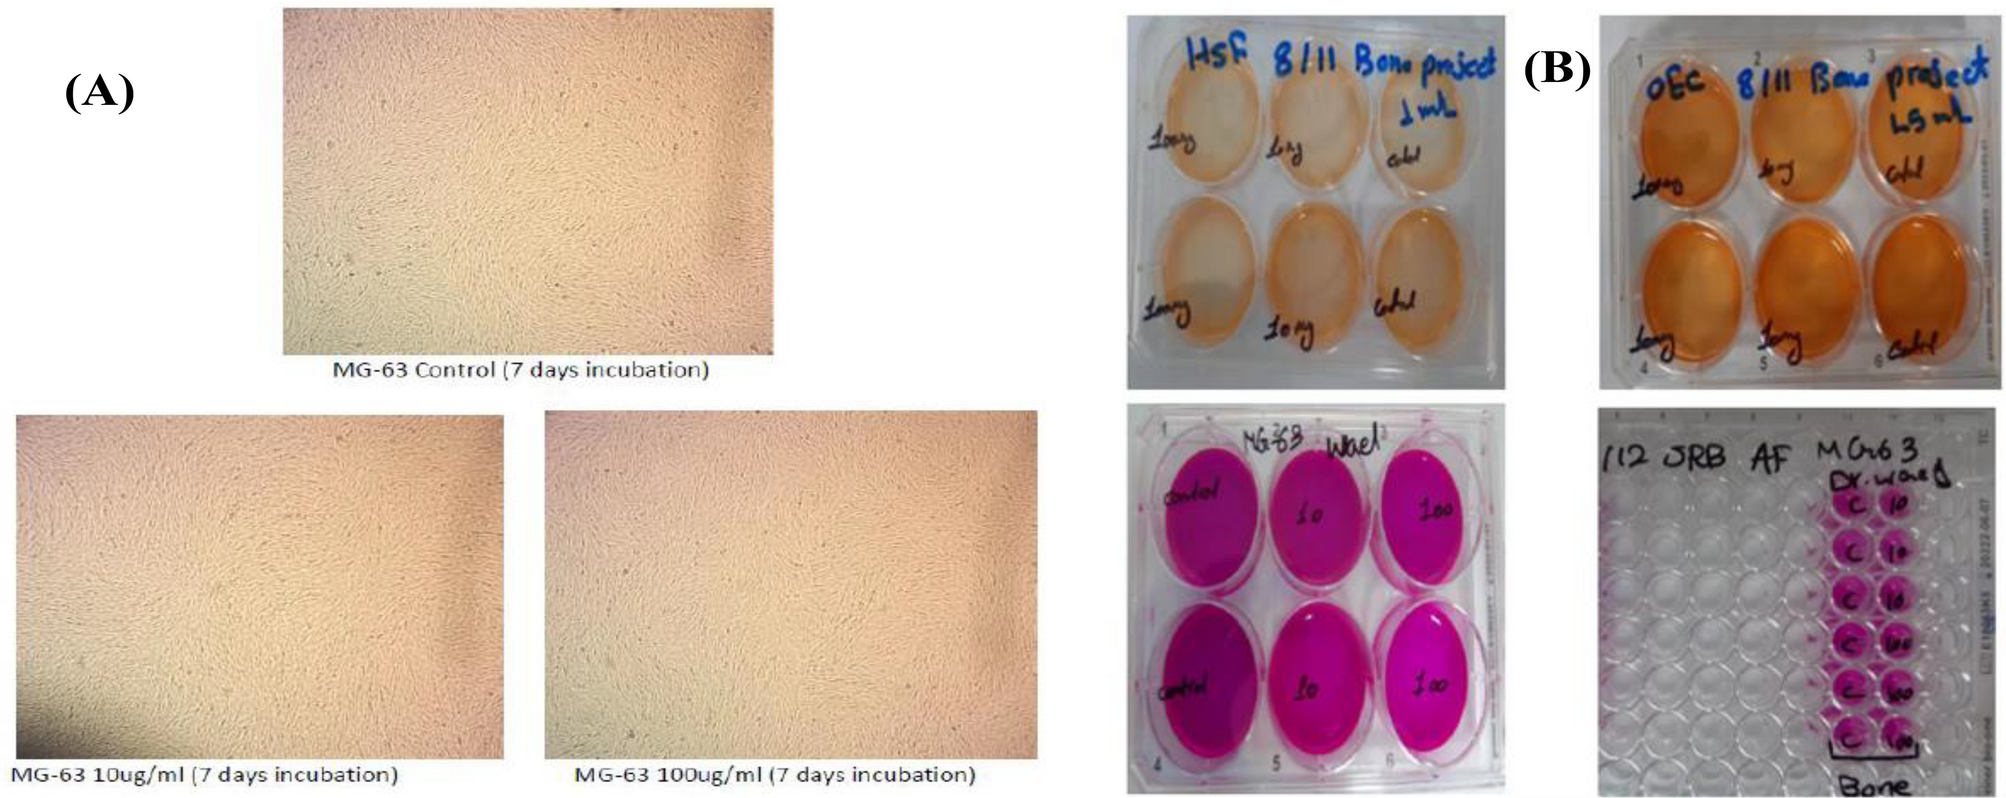
Figure 7

Figure 7
From: Biodegradable suture development-based albumin composites for tissue engineering applications
Cytotoxicity tests: (A) MG_63 samples during incubation. (B) OEC, HSF and MG-63 samples. Tested cells showed regular growth pattern and normal proliferation rate during the incubation periods.